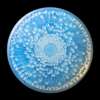

Lot 29

RENÉ LALIQUE (1860-1945)
TOKIO BOX, NO. 50


Auction: 25 April 2024 from 13:00 BST
£756
Description
designed 1921
opalescent
moulded LALIQUE
(2)
Dimensions
17cm (6 ¾in) diameter



Lot 29



Auction: 25 April 2024 from 13:00 BST
designed 1921
opalescent
moulded LALIQUE
(2)
17cm (6 ¾in) diameter